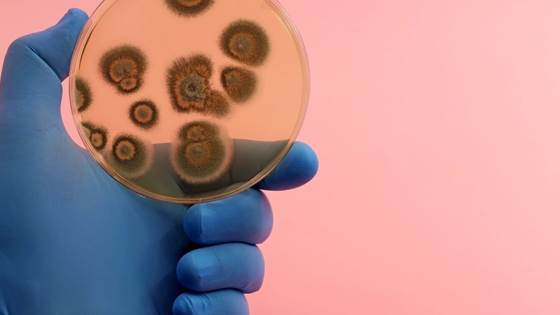

The wrong type of plumbing can increase the risk of Legionnaires’ disease
SINTEF researchers have been testing different types of water distribution cabinets. Cabinets that combine the distribution of both domestic tap water and water for floor heating, are now shown to represent an unnecessary risk of Legionnaires...